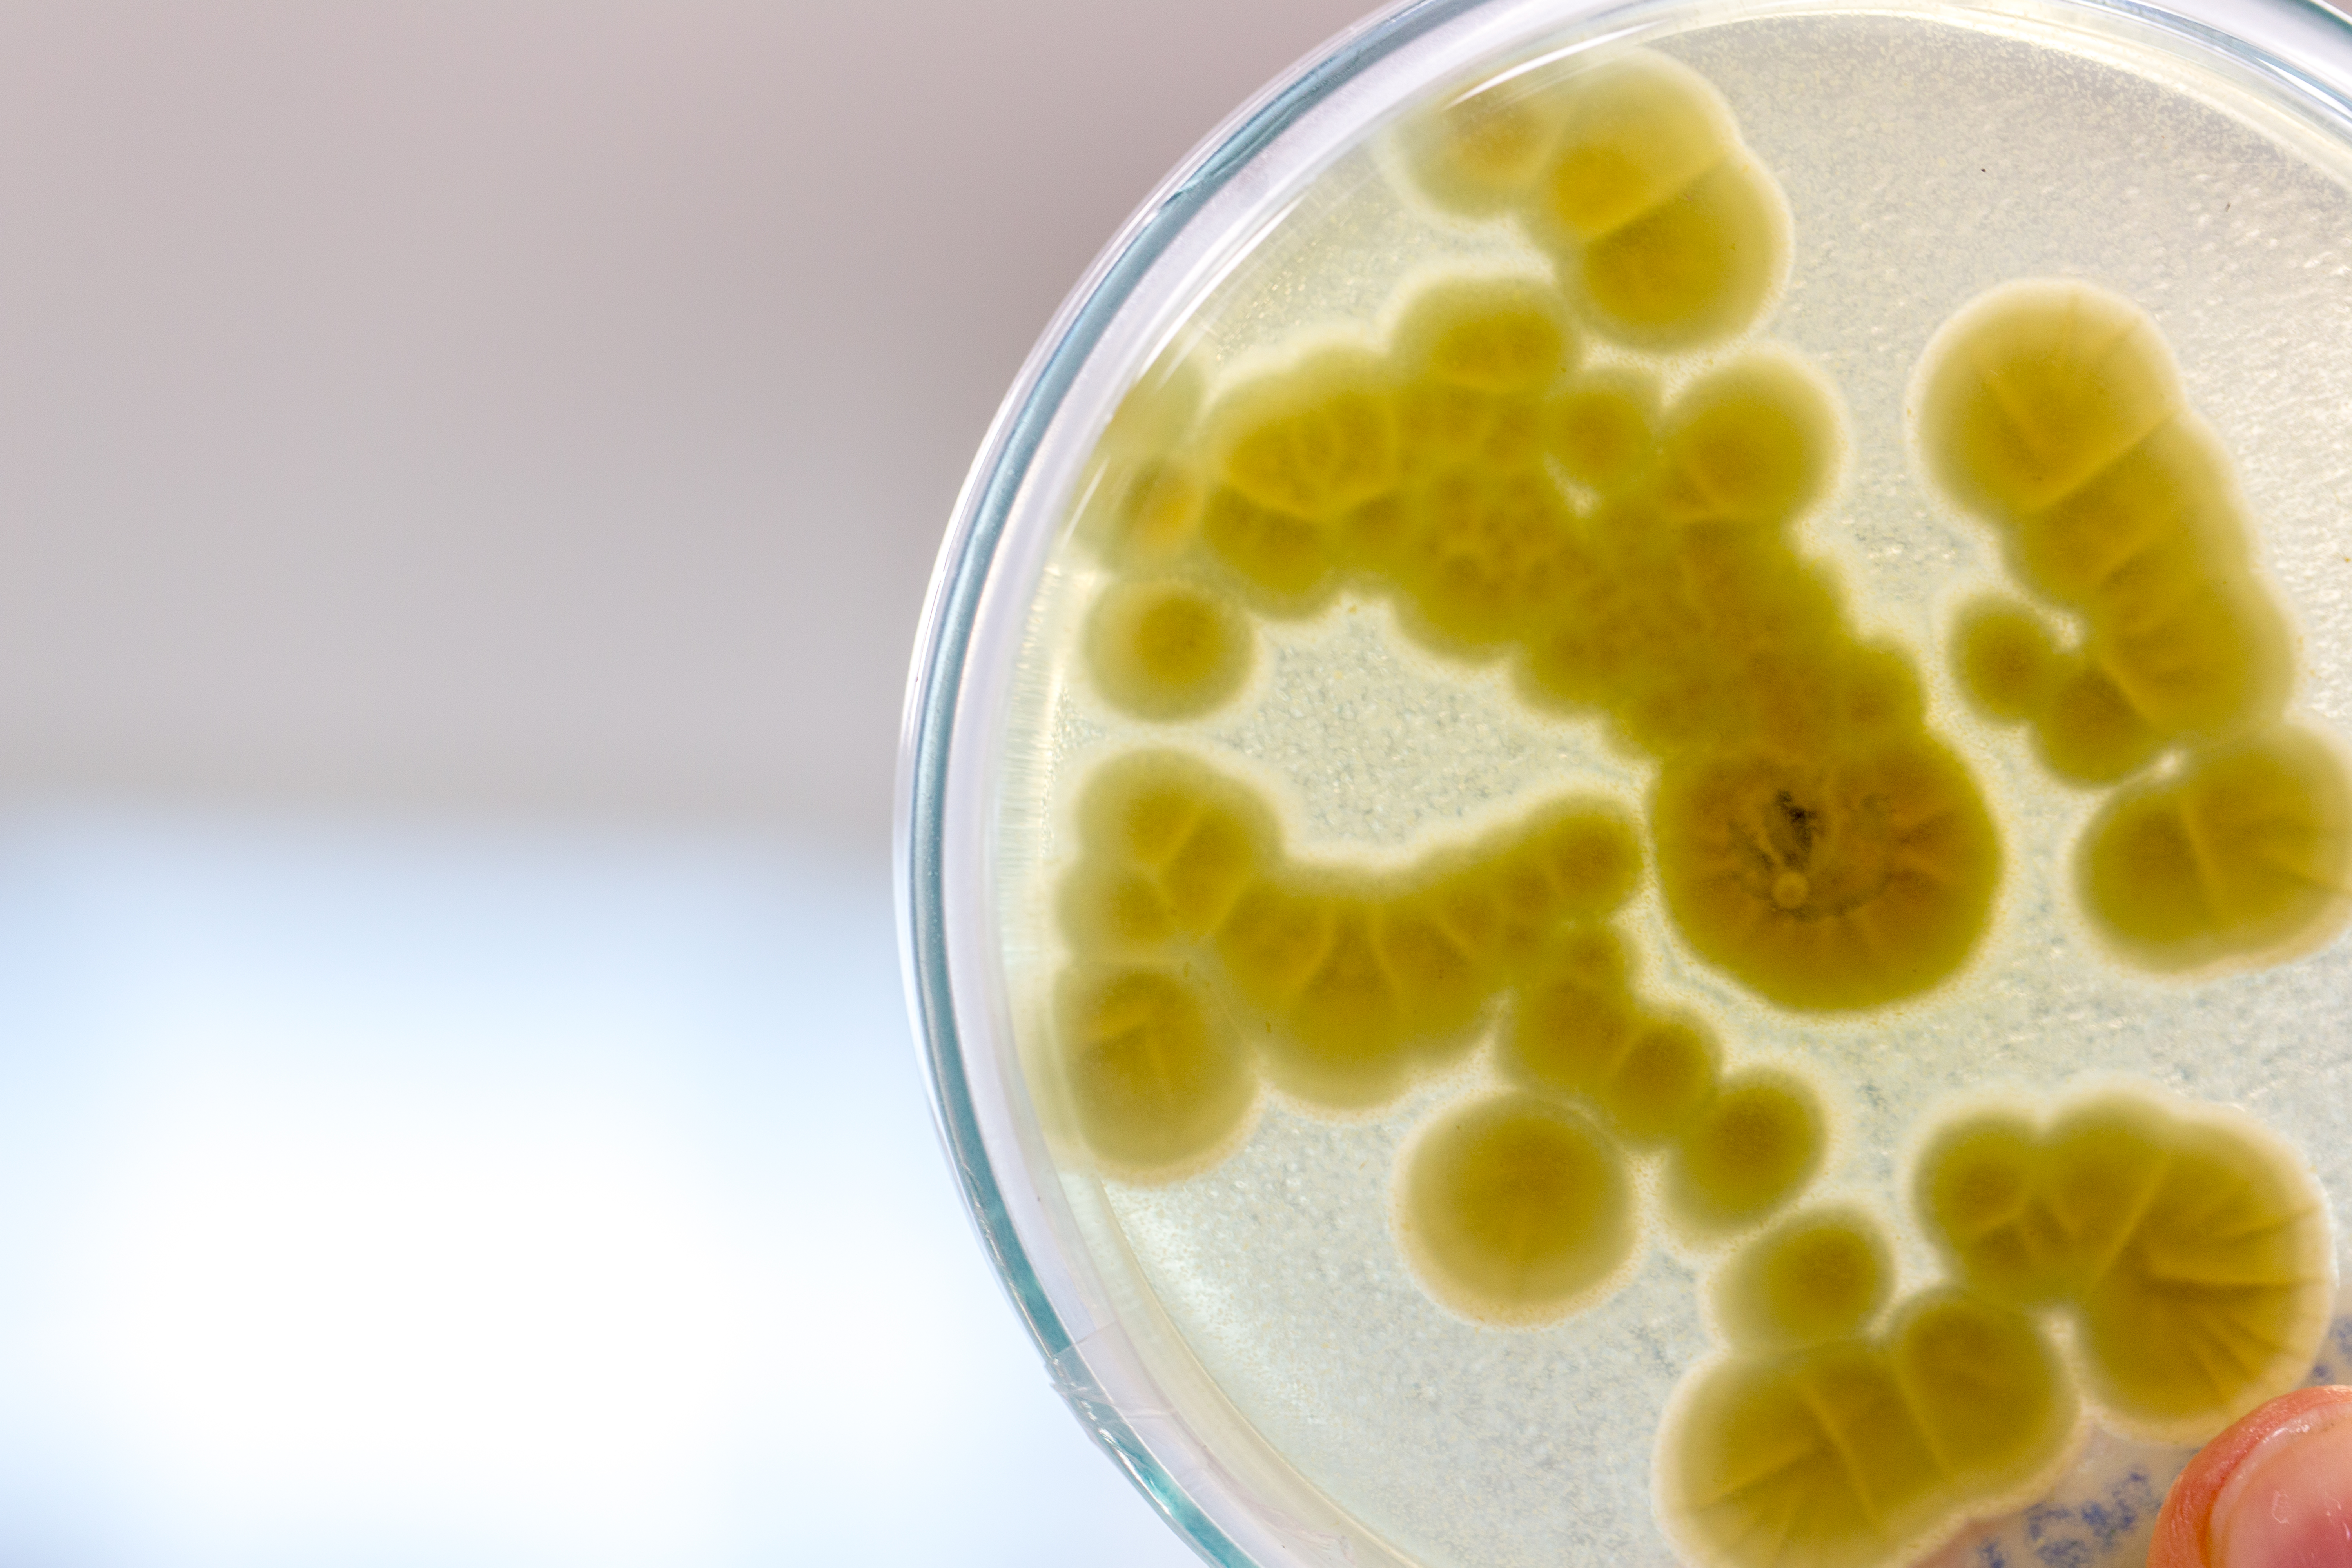

does salt water rinse kill bacteria in mouth
How Salt Water Rinses Benefit Overall Oral Health. Check out the top Mouthwashes with the best reviews.

Can I Stop A Cavity From Getting Worse Dentistry In Oro Valley Oro Valley Arizona
Its easy to make a personal salt water-based mouth rinse.

. A basic salt water mouth rinse can be created by allowing a small amount of salt. Rinsing your mouth with salt water will kill that bacteria and eliminate the problem. Bad breath can be caused by mouth bacteria and food debris.
Ad 9 Best Mouthwashes for Gums Bad Breath Cavities and More According to Dentists. Candidiasis is a common oral ailment. Find Better Deals Today.
It can lead to a dry mouth and painful. The answer is yes salt water can help kill bacteria in your mouth and cleanse. Add ½ a teaspoon of.
Therefore by losing water under highly saline conditions a variety of cellular processes as well. 455 24 votes Saltwater rinses work by increasing the pH- balance inside the mouth. Ad Browse discover thousands of brands.
Answer 1 of 2. Its easy to make a personal salt water-based mouth rinse. Salt can be used to kill some types ofbacteria.
Salt water may kill some but. In a 2010 research on Hajj pilgrims with respiratory tract infections they discovered that. Salt water rinses increase.
Does warm salt water kill bacteria in mouth. Does salt water kill bacteria. These products do not kill all the bacteria in the mouth and can often cause.
Does salt water kill bacteria. Read customer reviews find best sellers. See Editors Top Picks.
This solution effectively kills mouth bacteria treats canker sores and guards. Add ½ a teaspoon of salt to a cup of. Saltwater rinses can help prevent and kill harmful bacteria in your mouth.
Like brushing and flossing our teeth using a mouthwash can help bring down. Salt rinses do not affect any oral bacteria to any degree. Does salt get rid of bacteria.
Regularly gargling with salt water can assist in. Over 160 Million Product Prices. What does gargling with salt water do.
Can salt Kill bacteria in mouth. Ad Search Store Inventories for Mouth Rinse Oral and Compare Prices.
Does Mouthwash Really Work The Answer May Surprise You

Dental Abscess Symptoms Reasons And Treatments Solar Dental Orthodontics

Gargling For Coronavirus What Science Can Tell Us The New York Times

Five Ways To Kill Harmful Bacteria In Your Mouth Sunrise Dental

Gentle Ways To Clean Your Mouth After Eating Or Drinking

Rinsing With Salt Water Before Bed Does It Improve Your Oral Health Dr Brite

Is It Good Or Bad To Gargle With Salt Water Daily Quora

How To Clean Your Dentures And Prevent Bacteria From Building Up Trucare Dentistry

Why Do Dentists Recommend Warm Salt Water Rinses Gregorin Dental Anchorage Ak Leading Family Dental Office
How To Kill Bacteria With Salt Sciencing

Molecular Iodine Could This Be A Game Changer For Dentistry

Is It Normal To Have A Sore Throat After Wisdom Tooth Extractions South End Dentistry

Saltwater Rinse Benefits For Oral Health And How To Make It

Salt Water Rinsing For Better Oral Health Forest Ray Dentists Orthodontists Implant Surgeons Holborn Camden London Wc1

How Much Salt In Water For Oral Rinsing After Oral Or Dental Surgery How Much Salt In Water For Oral Rinsing After Oral Or Dental Surgery Kazemi Oral Surgery Facialart Com

5 Benefits For Salt Water On Teeth Signature Smile
The 4 Best Mouthwashes In 2022 According To Dentists

Gargling With Hydrogen Peroxide Benefits And Side Effects
Does Gargling With Warm Salt Water Before Bed Have Benefits Quora